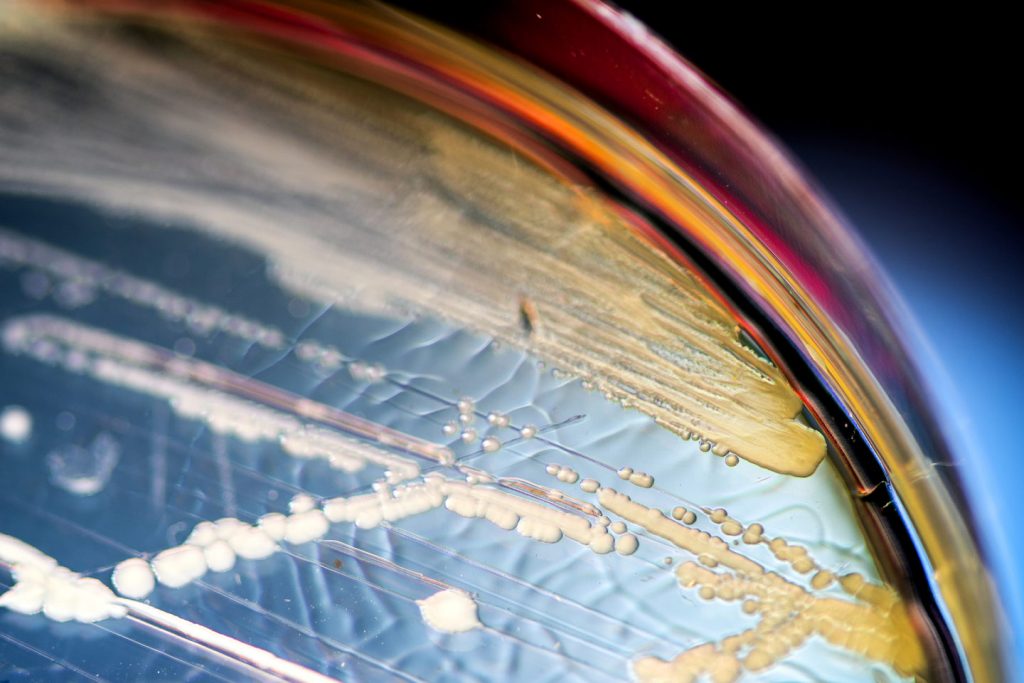
gut microbiome

Lyme Blog Posts
Are antibiotics useful for treating chronic Lyme disease patients? MyLymeData study provides some answers.
One of the questions we have sought to answer through our MyLymeData patient registry: Why do some people improve substantially with antibiotic treatment, while others…
LYME SCI: 12 ways you can help yourself manage chronic pain
Chronic pain–defined as ongoing pain that continues for longer than six months–is a common complaint of patients with persistent Lyme disease. The CDC estimates that…
Gut bacteria–an objective test for chronic Lyme disease?
by Emily Arntsen, Northeastern University Fatigue, muscles aches, brain fog—are these symptoms of chronic Lyme disease, or merely side effects of the daily grind of…
Would my son have his Lyme diagnosis without my mother’s instinct?
by Arlene Brailey For eight years, my son has been fighting a war against Lyme disease, with me alongside him. I have endured countless sleepless…
TOUCHED BY LYME: Resources to get you going in the right direction
LymeDisease.org is one of the foremost Lyme patient advocacy organizations in the United States. We provide a wealth of information on our website–about ticks, Lyme…
TOUCHED BY LYME: Walker & Shapiro fail to change report’s Chapter 7
The federal Tick-Borne Disease Working Group held another online meeting Tuesday. Its upcoming Report to Congress continues to inch towards completion. At this stage of…
LYME SCI: Feds adopt “national strategy” for vector-borne diseases
The Kay Hagan Tick Act, passed in 2019, called for the US Department of Health and Human Services (HHS) to develop a national strategy to…
Here’s our summary of TBD Working Group’s Sept. 22 meeting, in tweets
The federal Tick-Borne Disease Working Group met online September 22. The panel continued to work its way through its proposed Report to Congress. LymeDisease.org’s Lonnie…
TOUCHED BY LYME: Will Working Group acknowledge patient voices?
Prior to this past Tuesday, the last time the public tuned in for an online meeting of the Tick-Borne Disease Working Group was July 8….
Here’s our summary of Sept. 15 TBD Working Group meeting, in tweets
The federal Tick-Borne Disease Working Group met online September 15. The panel continued to work its way through its proposed Report to Congress. LymeDisease.org blogger…
Dr. Eva Sapi makes great strides in Lyme disease and cancer research
By Renee Chmiel, University of New Haven Eva Sapi, Ph.D., has long been on the front lines in the search for a cure for Lyme…
Tuttle directs pointed questions to TBD Working Group member Shapiro
Carl Tuttle, a long-time Lyme activist from New Hampshire, gave the following remarks by telephone to the Tick-Borne Disease Working Group on Sept. 15. This…